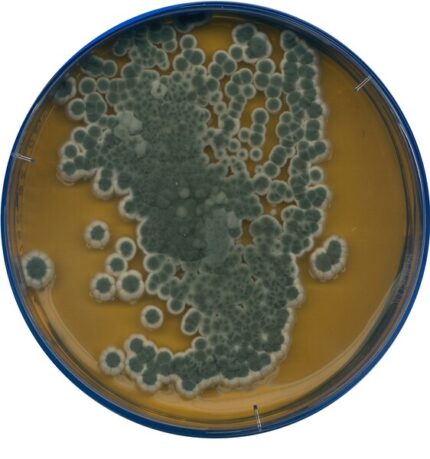
محیط کشت مالت اکستراک, محیط کشت مالت اکستراک اگار , 105398 , Malt Extract Agar

محیط کشت آندو اگار بیس کد مرک ۱۰۴۰۴۴
جهت خرید محیط کشت آندو اگار بیس کد مرک 104044 اصل و با کیفیتی تضمینی، برند مرک از آرمان کیمیا زیست، تامین کننده مواد شیمیایی آزمایشگاهی با بیش از ۳۰ سال سابقه
محیط کشت آندو اگار بیس کد مرک ۱۰۴۰۴۴: ابزاری حیاتی در میکروبیولوژی
در دنیای پیچیده میکروبیولوژی، تشخیص و جداسازی باکتریهای مختلف از اهمیت بالایی برخوردار است. محیط کشت آندو اگار بیس، با کد مرک ۱۰۴۰۴۴، یکی از ابزارهای قدرتمند و قابل اعتماد در این زمینه است. این محیط کشت با فراهم کردن شرایط بهینه برای رشد و تمایز باکتریهای رودهای، به ویژه کلیفرمها، در آزمایشگاههای تشخیص طبی، صنایع غذایی، و تحقیقات میکروبیولوژی کاربرد گستردهای دارد.
محیط کشت آندو اگار بیس (Endo Agar Base)، یک محیط کشت افتراقی و انتخابی است که برای شناسایی و شمارش باکتریهای کلیفرم در نمونههای مختلف مانند آب، غذا، و نمونههای بالینی طراحی شده است. ترکیبات شیمیایی این محیط کشت به گونهای است که رشد باکتریهای گرم مثبت را مهار کرده و امکان رشد و تمایز باکتریهای گرم منفی، به ویژه کلیفرمها را فراهم میکند.
اطلاعات فیزیکوشیمیایی:
- شکل ظاهری: پودر کرم رنگ
- pH (محلول ۱.۵% در دمای ۲۵ درجه سانتیگراد): 7.۴ ± ۰.۲
- حلالیت: محلول در آب (۱۵ گرم در لیتر)
- شرایط نگهداری: در دمای ۱۵ تا ۲۵ درجه سانتیگراد، در محیط خشک و دور از نور مستقیم خورشید نگهداری شود.
کاربردها:
محیط کشت آندو اگار بیس در صنایع و آزمایشگاههای مختلف کاربردهای وسیعی دارد، از جمله:
- آزمایشگاههای تشخیص طبی: تشخیص و جداسازی باکتریهای کلیفرم در نمونههای بالینی مانند ادرار، مدفوع، و خون
- صنایع غذایی: کنترل کیفیت میکروبی مواد غذایی و شناسایی آلودگیهای احتمالی با باکتریهای کلیفرم
- تصفیه آب و فاضلاب: پایش کیفیت میکروبی آب و شناسایی باکتریهای نشانگر آلودگی مدفوعی
- تحقیقات میکروبیولوژی: مطالعه و شناسایی باکتریهای رودهای
حجمها:
محیط کشت آندو اگار بیس در بستهبندیهای مختلف از جمله ۵۰۰ گرمی و ۱ کیلوگرمی عرضه میشود. انتخاب حجم مناسب بستگی به نیاز و میزان مصرف آزمایشگاه یا صنعت دارد.
مزایای استفاده از محیط کشت آندو اگار بیس کد مرک ۱۰۴۰۴۴:
- کیفیت بالا و قابل اعتماد: تولید شده توسط شرکت مرک، یکی از پیشروان جهانی در زمینه تولید مواد شیمیایی و آزمایشگاهی
- سهولت استفاده: آمادهسازی آسان و سریع محیط کشت
- تشخیص دقیق: امکان تمایز باکتریهای کلیفرم از سایر باکتریهای گرم منفی
- کاربردهای گسترده: مناسب برای استفاده در صنایع و آزمایشگاههای مختلف
نتیجهگیری:
محیط کشت آندو اگار بیس کد مرک ۱۰۴۰۴۴، یک ابزار ضروری و کارآمد برای تشخیص و جداسازی باکتریهای کلیفرم است. با کیفیت بالا، سهولت استفاده، و دقت تشخیص، این محیط کشت به یکی از انتخابهای برتر متخصصان میکروبیولوژی در سراسر جهان تبدیل شده است. اگر به دنبال یک محیط کشت قابل اعتماد و کارآمد برای تشخیص باکتریهای کلیفرم هستید، محیط کشت آندو اگار بیس کد مرک ۱۰۴۰۴۴ را به شما پیشنهاد میکنیم.

![104044_ENDO-Agar_Shigella flexneri[104044_ENDO-Agar_Shigella flexneri-ALL] (1) محیط کشت آندو اگار بیس, کد مرک 104044, Endo Agar Base](https://armanbio.com/wp-content/uploads/2024/09/104044_ENDO-Agar_Shigella-flexneri104044_ENDO-Agar_Shigella-flexneri-ALL-1.jpg)






دیدگاهها
هیچ دیدگاهی برای این محصول نوشته نشده است.